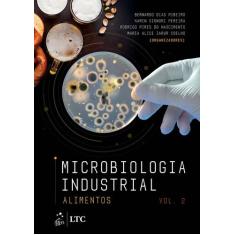

Microbiologia Industrial - Volume 2 - Bernardo Ribeiro - 9788535287257
Criar alerta de preço
Ofertas destacadas
Menor preço
Publicidade
Ficha técnica
Informações Básicas
| ISBN | 9788535287257 |
|---|---|
| ISBN-10 | 8535287256 |
| Título | Microbiologia Industrial - Volume 2 |
| Autor | Bernardo Ribeiro |
| Editora | Elsevier Acadêmico |
Descrição
O menor preço encontrado no Brasil para Microbiologia Industrial - Volume 2 - Bernardo Ribeiro - 9788535287257 atualmente é R$ 358,92.
Publicidade
Publicidade
Publicidade